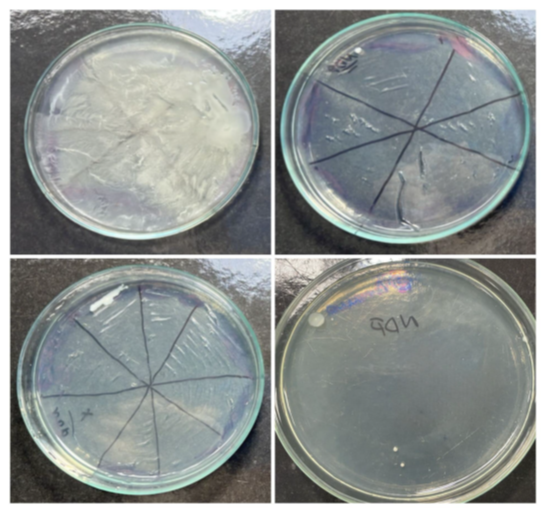

Journal of
eISSN: 2373-4345


Research Article Volume 16 Issue 3
1São Francisco University, Brazil
2São Paulo University, Brazil
3Taubaté University, Brazil
Correspondence: Miguel Simão Haddad Filho, Professor of Dentistry at the University of São Francisco, Bragança PaulistaSP, Brazil
Received: August 30, 2025 | Published: September 19, 2025
Citation: Filho MSH, Ferreira FP, Tognetti VM,et al. Presence of microorganisms on the surface and inside of the NDP® intracanal medication tube used in endodontics. J Dent Health Oral Disord Ther. 2025;16(3):109-116. DOI: 10.15406/jdhodt.2025.16.00653
The presence of microorganisms on the surface and inside NDP® intracanal medication tubes was evaluated. This medication is commonly used in endodontic treatment due to its anti-inflammatory and antimicrobial action. The research was conducted through a laboratory experiment with 21 tubes previously used by dental students at the university clinic and one unused tube as a control. A test was performed by rolling the tube before and after use to investigate surface contamination, in addition to collecting internal contents, which were incubated in aerobic and anaerobic culture media. The results revealed that 57.14% of the tubes showed microbial growth in an aerobic environment, suggesting environmental contamination, and 42.86% in anaerobic conditions, indicating the possible presence of microorganisms from the oral microbiota. These findings highlight the contamination of the tubes mainly due to improper handling and incorrect storage, which can compromise the effectiveness of endodontic treatment and, more seriously, the patient's systemic health. It is concluded that the reuse of these tubes represents a significant biological risk and that strict disinfection protocols should be adopted. The single use of NDP® medication tubes is recommended, in addition to the development of reduced-volume packaging and immediate disposal, as a preventive measure to ensure biosafety in dental care.
Keywords: intracanal medication, biosafety, cross contamination, desinfection and antimicrobial action
Root canal cleaning is a fundamental step in the remission of signs and symptoms, especially those associated with infection. Although adequate instrumentation is performed after chemical-surgical preparation, bacteria are present inside the canal, especially in the dentinal tubules, making it necessary to use intracanal medication to prevent bacterial growth. On the one hand, the aim is to control bacterial growth, promoting tissue repair and reducing pain; on the other hand, it is important to take every precaution to prevent infection of all instruments and materials. Intracanal medication refers to medications placed inside the root canal after chemical-surgical preparation that help eliminate bacteria, reduce inflammation, and neutralize tissue residues, reducing inflammation of the periapical tissues when performed over several appointments.
Silva Júnior et al.,1 analyzed unused anesthetic tubes and detected the presence of gram-negative bacilli, gram-positive staphylococci, and fungi in 25 of the 38 samples examined. This contamination may come from the rubber and metal caps of the tubes due to improper storage and transportation. In fact, piercing the cap with the needle would allow bacteria to pass into the tube's contents, resulting in infections at the time of application.
Basson et al.,2 warn that during endodontic procedures, the surface of root canals can be contaminated by microorganisms, which, upon coming into contact with the practitioner's gloves or instruments, can be transferred to the surgical field, increasing the risk of infections, edema, and discomfort to the patient.
Lemos3 reported that during endodontic procedures, the professional encounters conditions that require the use of intra-canal medication, especially in teeth with live pulp. Although the success of each treatment depends on the correct diagnosis and course of action, it should be noted that teeth with live pulp are free from contamination, understanding that the main cause of damage to pulp tissue is microorganisms, with the presence of dental caries and the direct diffusion of bacteria through the dentinal tubules contributing to the onset of pulp inflammation.
According to the Brazilian Health Regulatory Agency ANVISA,4 biosafety is the condition of protection obtained through a set of measures aimed at preventing, controlling, minimizing, or eliminating risks inherent in activities that may pose a threat to human, animal, or environmental health. Thus, infection control in dentistry can be ensured through guidelines and standards, including the operative stage of intra-canal medication.
Haddad Filho et al.,5 analyzed microbiological contamination in 80 briefcases used by undergraduate dentistry students to transport materials at four higher education institutions in the state of São Paulo, one public and three private. Laboratory analysis revealed microbiological contamination in all units evaluated and Gram-positive cocci with different hemolytic patterns, as well as the presence of Gram-negative bacilli, including coliforms and enterobacteria in some of the samples. This research reveals that various materials stored in the cases, such as anesthetics, auxiliary chemicals, and intracanal medications in tubes, had potentially contaminated surfaces, favoring the introduction of microorganisms into the clinical environment. The improper handling of these items, combined with the absence of standardized disinfection procedures, poses a significant risk to the biosafety of patients, students, teachers, and health professionals, which indicates a lack of effective decontamination practices. Given this, the study points out that cases should be properly sanitized, especially their internal surfaces as well as the materials transported, in order to prevent the spread of microorganisms, including those classified as moderate to high risk pathogens.
Porto6 defines biosafety as a set of actions aimed at preventing, minimizing, or eliminating risks inherent in research, production, teaching, development, technology, and service provision activities aimed at human and animal health, environmental preservation, and quality of results. However, there is still negligence regarding consumables stored in plastic cases with dividers, transported by undergraduate students.
Pimentel et al.,7 reported that cross-infection control in Brazil shows that both dentistry students and professionals working in the field do not adequately apply biosafety standards in their clinical routine. In addition, sterilization processes are flawed and lack a standardized protocol among dental surgeons, which further reinforces the need to disseminate the importance of preventive measures and implement strict protocols in academic centers, contributing to the formation and consolidation of safe practices throughout professional life.
Haddad Filho8 comments that various types of intracanal medications are used in endodontic therapy, depending on the diagnosis. Among them is the intracanal medication called NDP® used in cases of live pulp where total or partial pulpectomy is performed, after chemical-surgical preparation is completed or not, as well as a medication alternative in cases of pulp necrosis after preparation is completed. This medication consists of a combination of a corticosteroid anti-inflammatory and an antimicrobial agent, providing both anti-inflammatory and antiseptic therapeutic action after canal instrumentation. NDP® is prepared in compounding pharmacies and packaged in 1.0 mL plastic tubes, with the same characteristics as anesthetic tubes used in dentistry, which facilitates its application inside the canal using a carpule syringe and a short 30g injection needle. After inserting the medication, it is recommended to place a sterile cotton dressing in the pulp chamber and then perform a temporary restoration to ensure adequate isolation of the root canal system. The anti-inflammatory component is dexamethasone phosphate, a potent corticosteroid considered safe from a biological standpoint, while the antimicrobial agent is paramonoclorophenol, known for its effective activity against microorganisms present in the root canal. These active ingredients are associated with a viscous vehicle formed by polyethylene glycol 400 and rhinose in equal parts, comprising a total volume of 1.0 mL, with the final formulation consisting of 0.32g of dexamethasone phosphate and 2g of paramonoclorophenol.
Ranjbari et al.,9 stated that infection control is one of the important aspects in dentistry. Oral and maxillofacial surgery is one of the most sensitive fields in dentistry, in which infection control is important and a sterile surgical set is essential. Manufacturers only guarantee the sterility of the anesthetic, not the sterility of its external surface. They recommend alcohol to sterilize the external surface, especially the cartridge diaphragm. On the other hand, studies have shown contamination of external surfaces in anesthetic cartridges in varying amounts. The evaluation of possible microbial contamination of the surfaces of anesthetic cartridges was the objective of this study. During this descriptive experimental study, random sampling was performed, and 1,200 Iranian and imported cartridges were transferred to different culture media (aerobic, anaerobic, and fungal). After 24-48 hours of incubation, the samples were transferred to specific culture media. The cultured bacteria were stained using the Gram staining method. The study was conducted over a period of 6 months. They found that 6.3% of aerobic cultures, 1.8% of anaerobic cultures, and 0.7% of fungal cultures were contaminated by different types of microorganisms collected from the cartridges. They concluded that the contamination of the cartridges is not negligible and that placing them directly in the sterile surgical set is not recommended.
Porfírio10 confirmed that dexamethasone is a synthetic glucocorticoid widely used as a steroidal anti-inflammatory drug. This drug acts by reducing the lymphocyte immune response through gene expression modulation, giving it an immunosuppressive action similar to cortisol. The mechanism of dexamethasone includes the inhibition of inflammatory cytokines and enzymes such as cyclooxygenases 1 and 2. Its ability to easily cross the cell membrane and act on the cell nucleus makes it effective in multiple tissues. However, the side effects are significant, especially when used chronically, such as systemic and immunological complications. Dexamethasone has a broad therapeutic spectrum and is a valuable tool in clinical practice, but its use should be cautious and individualized, considering the risks of adverse effects.
Pauletti et al.,11 evaluated the effectiveness of disinfecting anesthetic tubes in vitro for outpatient surgical procedures using 70% alcohol (A), iodine compound (I), 0.12% aqueous chlorhexidine digluconate solution (CA 0.12%), 2% aqueous chlorhexidine digluconate solution (CA 2%), 0.12% alcoholic chlorhexidine digluconate solution (CAL 0.12%), and 2% alcoholic chlorhexidine digluconate solution (CAL 2%). Distilled water (D) and no agent (NA) were used as control groups. After exposure times of 5, 10, and 15 minutes to the disinfectants, samples were collected, inoculated in Petri dishes, and incubated at 37°C for 48 hours to verify the presence or absence of Colony Forming Units (CFU). The study revealed that A and CA 0.12% were effective only after 15 minutes of exposure. The CA 2%, CAL 0.12%, CAL 2%, and I solutions were effective at the experimental times of 5, 10, and 15 minutes. In the control groups (D and SN), there was bacterial growth at all experimental times. They concluded that the agents tested that demonstrated disinfection efficacy in just 5 minutes, combined with low cost and ease of handling, were: I, CA 2%, CAL 0.12%, and CAL 2%. The results of the control group highlight the need to disinfect the tubes prior to use.
Dutra et al.,12 proposed to evaluate the effectiveness of disinfectant solutions in reducing the microbial load in anesthetic tubes and, for this purpose, selected 70% ethyl alcohol, 7% stabilized chlorine dioxide, and 5.2% benzalkonium chloride with 3.5% polyhexamethylene biguanide as disinfectant products, and 31 anesthetic tubes randomly selected from the storage room of a dental school in northern Rio Grande do Sul. Positive controls without any disinfection and negative controls (rubbing with sterile distilled water) were established. The presence of cloudiness in the liquid medium and the appearance of colonies in the solid medium were indicative of microbial growth. The study detected the presence of Gram-positive and Gram-negative cocci in the controls, confirming that the tubes were contaminated and requiring microbial control prior to use, although no specific identification of the microorganisms was performed. Although 70% alcohol is classified as a moderate-strength disinfectant, the results obtained by this author indicated that it, like 3.5% polyhexamethylene biguanide, demonstrated efficacy in disinfecting the tubes when applied by rubbing for 10, 20, and 30 seconds, being more efficient than 7% stabilized chlorine dioxide, which showed microbial growth in the rubbing methods. However, the immersion method of none of the three disinfectants showed satisfactory results. The research highlights the relevance disinfection of anesthetic tubes, which represent potential sources of contamination for patients during dental procedures. After opening the packaging, anesthetic tubes are usually stored in their own boxes, remaining exposed to the environment and favoring contamination of the outer surface. This contamination transforms the tubes into potential sources of cross-infection, especially in critical procedures such as surgeries.
Lopes and Siqueira Jr13 stated that for endodontic treatment to be successful, it is necessary to use intracanal medication (ICM) to reduce inflammation in the periapical tissues, control exudation, enhance decontamination, act as a physical against reinfections, remove organic matter, neutralize microbial toxins, and stimulate repair by mineralized tissue. The use of intracanal medications plays a fundamental role in the effectiveness of disinfection and can also be used to control microbial proliferation between sessions and eliminate the microorganism responsible for the intracanal infection already present. In addition, these substances can promote tissue repair, contribute to canal sealing, and aid in pain relief.
Setzer et al.,14 mentioned that Endodontics is the dental specialty that aims to treat diseases affecting the dental pulp and periapical tissues, resolving painful symptoms, preserving the tooth, and restoring function and aesthetics. Therefore, one of the greatest challenges of endodontic therapy is the disinfection of the root canal system, efficiently eliminating microorganisms present and preventing new contamination. This is made possible through proper instrumentation, irrigation with antimicrobial agents, the use of intracanal medication, and canal filling.
Jesus and Câmara15 commented that biosafety measures for prevention and protection against occupational risks in dentistry are learned during undergraduate studies. The importance of such measures became evident during the COVID-19 pandemic. This cross-sectional, exploratory, and descriptive study aimed to analyze biosafety as a curricular component of Brazilian dental schools. The study population consisted of coordinators of undergraduate dental programs in Brazil, who were surveyed using an online questionnaire between November 2019 and February 2020. The results were analyzed descriptively and aggregately. Of the 68 responding courses, 43 had a specific Biosafety discipline, all of which were mandatory, 5 theoretical, and 38 theoretical-practical. The main reasons for the existence of the specific discipline are professional training/practice; establishment of good work practices; and presentation of concepts/standards. The main reason for not having a specific subject is the adoption of an integrated/interdisciplinary curriculum. The syllabus is more extensive in courses with a specific subject, with a predominance of topics related to infection prevention and control in both groups. Among the bibliographic references adopted, there was a predominance of textbooks and manuscripts produced by Brazilian government institutions, with most courses reporting that they routinely review the references. Twenty-eight names were identified for the subject, offered mainly in the early stages of the course and as a prerequisite for other subjects. It is considered ideal that the curriculum of undergraduate dentistry courses include a specific, mandatory course on Biosafety in the first year, with reinforcement of the topic throughout the course, especially in courses with practical activities. Some topics on Biosafety are suggested for the curriculum content.
Silva Júnior et al.16 emphasized that the following biosafety practices must be observed in dental clinics: cleaning and disinfection of the environment must be performed by trained professionals using appropriate PPE; suction hoses must be sanitized with chlorine-based disinfectant or another appropriate disinfectant after each patient; sterile and autoclaved handpieces (high and low speed) are used between each patient; most procedures are performed with four hands; a rubber dam is used during treatment; the high-powered suction system (vacuum pump) is used correctly; if the recommended disassembly is performed after each treatment; if the reuse of the N95/PFF2 mask (or equivalent) follows safe storage and usage time criteria; and if the face shield is cleaned and disinfected with 70% alcohol or another recommended product after each treatment.
Cruz et al.,17 conducted a review of articles aimed at controlling postoperative pain. The main results were that dexamethasone, administered orally, intracanal, intraligamentary, and also by infiltrative/submucosal injections, showed significant effectiveness in relieving pain after endodontic treatment in the first 24 hours, which is the period when most patients report pain. Thus, corticosteroids, such as dexamethasone, played a very important role in endodontic therapy, which aims to inhibit inflammatory responses.
Mondini et al.,18 conducted a study at the Immunology Laboratory of the Regional University of Blumenau (Furb) to evaluate the efficiency of three chemical agents in disinfecting the surfaces of glass anesthetic tubes containing 1.8 ml of anesthetic solution. They used 2% aqueous chlorhexidine gluconate, 0.5% alcoholic chlorhexidine gluconate, and 10% povidone-iodine (PVPI). The 120 samples were divided into four groups: control, aqueous chlorhexidine, alcoholic chlorhexidine, and PVPI. After being removed from their packaging, all tubes were contaminated with three different bacterial species selected for their common occurrence in the oral cavity, dental environments, and salivary aerosol (Escherichia coli, Staphylococcus aureus, and Enterococcus faecalis). After contamination, the tubes were immersed in the chemical agents for three minutes, except for the control group. Then, the metal part of the tubes was rubbed with a sterile swab, which was placed in tubes containing previously sterilized BHI broth and incubated at 37°C for 5 days, with readings at 24, 48, 72, and 120 hours. After incubation, the material from the tubes with turbidity was collected for Gram staining and cultivation on Mueller Hinton Agar and MacConkey Agar plates, both previously sterilized. The plates were incubated at 37 °C for 5 days, and after bacterial growth, new samples were subjected to new plating and Gram staining to confirm the results. In cultures performed in liquid medium, all tubes in the control group showed bacterial proliferation, evidenced by the turbidity of the solution. In groups 2, 3, and 4, no microbial growth was detected. Thus, the study concluded that immersion of anesthetic tubes in 2% aqueous chlorhexidine gluconate, 0.5% alcoholic chlorhexidine gluconate, and 10% PVPI for 3 minutes was effective for disinfection. The relevance and applicability of this analysis in clinical dental practice is noteworthy, especially in non-surgical procedures, in which prior decontamination of the tubes is not usually performed. Thus, the need for prior disinfection is evident, since contamination can originate from the environment during clinical and surgical procedures.
Santos and Salles19 commented that cross-infection control is essential for the protection of dental staff, patients, and prosthetic laboratories. It is known that biosafety measures are used in dental practice. However, the decontamination of molds, models, and prosthetic work is not always done properly, given that there is a risk of contamination that must be eliminated. However, studies have shown that compliance with good practices is less than ideal, and therefore education of dentists and technicians regarding the problem is necessary. Thus, this research aimed to address the need for disinfection of materials, point out how this practice should be done, and contribute to the development of healthy dentistry. The research confirmed concerns that compliance with good practices is below ideal, highlighting the importance of raising awareness among those working in the field from the outset of their training, given the serious consequences that poor disinfection of materials can cause. It is considered that the proposed objectives were achieved, since it was possible to address the need for disinfection of materials, point out how this practice should be carried out, and thus contribute to the development of healthy dentistry by demonstrating the importance of rigorous hygiene and antisepsis in dental offices to control and prevent cross-infection in the dental office. It should be noted that in conducting this research, little specific content was found related to the topic discussed here. Therefore, the suggestion here is that more specific research on the topic be conducted, considering its importance and the known fact that prevention is always the best solution.
Oliveira20 confirmed that the decontamination of materials used in dentistry is essential to ensure the safety of both service users and healthcare professionals. This step involves cleaning and disinfecting all dental instruments and items in order to eradicate pathogenic microorganisms and prevent infections. Due to direct contact with bodily fluids, such as salivas and blood, during dental procedures, there is a high risk of disease transmission, which makes sanitization essential in combating cross-contamination. In addition, many of these infectious agents can remain viable for prolonged periods even outside their fluids. Thus, if preventive measures are not taken, the transmission of pathogens between patients, dentists, auxiliary staff, and dental technicians can occur frequently.
Therefore, the presence of contamination on the surface of the tube before and after use, as well as the presence of microorganisms inside these multi-use NDP intracanal medication tubes, may represent a significant risk of reinfection of the root canal system, compromising the success of endodontic treatment and exposing the patient to possible clinical complications that directly affect their oral and systemic health . Therefore, the purpose of this investigation was to evaluate the presence of microorganisms on the surface and inside NDP® intracanal medication tubes during intracanal medication application practices, investigating possible biosafety failures and risks of cross-contamination.
The experiment was conducted in the microbiology laboratory at São Francisco University (USF) using a laminar flow hood, a bacteriological culture incubator, anaerobic jars, disposable calibrated loops, and Petri dishes (Figure 1).
Twenty-one tubes of NDP® intracanal medication were collected prior to their use by students in a clinical setting, and one intact tube was collected for control purposes. The tubes were selected based on the following criteria: intact packaging, current expiration date, similar solution volume, and having been used at least once. Tubes with tampered packaging, expired expiration dates, and discrepant volumes were excluded from the analysis in order to maintain the standardization and accuracy of the study. The way in which this intracanal medication is commonly handled during endodontic treatment by undergraduate students was considered. Materials such as procedure gloves, short 30g injection needles (one for each medication tube), and sterile carpule syringes were used (Figure 2).

Figure 2 Carpule syringe, NDP® medication tube, and short gingival needle.
Source: The authors, 2025.
The contamination being transferred from one patient to another was investigated, testing the outer surface of an NDP® tube, which would be used in treatments during a given period, on nutrient agar. For this purpose, two plates were prepared for comparison: one labeled “Pre” (before use) and the other “Post” (after use).
The tube was initially sanitized and rolled over the surface of the culture medium using sterile gloves. The tube was then handed to the student, who used it during the clinic. At the end of the consultation, the tube was rolled over the culture medium again to check for contamination. Subsequently, the two plates were kept in an incubator (aerobiosis) for 48 hours at 37°C.
In order to collect the internal material, a step-by-step simulation of the dental procedure was performed with each medication tube. The tubes were inserted into the sterile carpule syringe and the needle was attached. Wearing gloves, five drops of the tube's contents were added to Nutrient Agar plates inside a laminar flow cabinet after sanitizing the tube's surface with 70% alcohol. The contents were streaked with the aid of a sterile loop (Figure 3).
Two plates were prepared for each tube, one incubated in aerobic conditions (presence of oxygen) at 37°C for 48 hours and the other incubated in anaerobic jars (absence of oxygen) at 37°C for 72 hours. An unused tube was used as a negative control. The results were read by visual inspection after the incubation period.
As shown in Figure 4, the tube holder at the beginning of the clinic had few microbial colonies, consistent with contact with the environment. In the test performed after use by the student, the outer surface of the tube holder was entirely contaminated with a high number of microorganisms, probably coming from the environment and the mouths of the patients treated.
This finding draws attention to possible cross-contamination between patients and a breach of biosafety rules.
As for the internal solution of the medication, of the 21 NDP® tubes evaluated, 12 showed microbial growth in aerobiosis, i.e., 57.14% of the total tubes (Figure 5), and in anaerobiosis, 9 were contaminated, i.e., 42.86% of the total tubes (Figure 6). The control tube showed no microbial growth.

Figure 5 Microbial growth in an aerobic environment, coming from the NDP® tube.
Source: The authors, 2025.
Figure 6 Microbial growth in an anaerobic environment, coming from the NDP® tube.
Source: The authors, 2025.
Aerobic incubation, for the most part, consists of bacteria and fungi from the environment, while anaerobic growth indicates a probable origin in the oral microbiota, suggesting cross-contamination between patients, carried by the NDP®. In addition, some tubes were more contaminated than others, with growth of different species. Growth in some tubes and not in others demonstrates a probable biosafety failure related to the student handling the tube.
One of Hippocrates' (460-370 BC) postulates states that, among the treatment options available, we must choose the one that causes the least harm to the patient. Applied to the present day, this should be dogmatic for all healthcare professionals, i.e., care and cure will be provided at the expense of strict biosafety and intervention protocols. It is worth remembering that we have recently experienced the worst public health crisis of all time, the COVID-19 pandemic, which, according to Jesus and Câmara,15 highlighted the need for biosafety as an essential condition for the safe performance of dental activities.
In fact, intracanal medication is used in daily endodontic practice, which is made possible by inserting medications into the root canal space after chemical-surgical preparation, helping especially in the elimination of bacteria, further disinfecting the canal and reducing inflammation of the periapical tissues.8
Therefore, although the accuracy of the use of intracanal medications is recognized, there is a progressive reduction in this practice, recognizing that the application of medications between sessions adds to the effectiveness of the treatment, but with the possibility of a high risk of reinfection between appointments, especially in cases of live pulp. In this regard, Lemos3 points out that teeth with live pulp are free from contamination. Therefore, there is a consensus among experts aimed at greater infection control.
The success of endodontic treatment, according to Lopes and Siqueira Jr13 Setzer et al.,14 is related to the cleaning and reduction of pathogenic bacteria due to the complexity of the root canal system and that, in the vast majority of cases, intracanal medication aids in chemical and surgical preparation. In Brazil, NDP endodontic solution is used, packaged in a box with five plastic tubes containing 1.0 ml each, whose purpose is to control periapical inflammation by complementing root canal disinfection, both in cases of live and dead pulp.
Evidence supports the hypothesis that it acts by destroying pathogenic microorganisms present in infected dentin and disinfecting the root canal system. NDP is often used in emergency treatments, after pulpectomy, or in cases of incomplete chemical-surgical preparation.
The evidence also supports Porfírio's10 hypothesis that dexamethasone, used as a steroidal anti-inflammatory, acts to decrease the lymphocyte immune response, playing an immunosuppressive role that includes inhibition of inflammatory cytokines and enzymes such as cyclooxygenases 1 and 2. It easily crosses the cell membrane and acts on the cell nucleus, becoming active in multiple tissues. As for side effects, when used repeatedly, systemic and immunological complications may occur. Therefore, in clinical practice, its use should be prudent and individualized, considering the risks of adverse effects. Evidently, Cruz et al.,17 when reviewing the literature, proposed to observe the control of postoperative pain, with the main results of dexamethasone, administered orally, intra-canal, intraligamentary, and also by infiltrative/submucosal injections, showing a significant effect in relieving pain in the first 24 hours after procedures, considering that this is when a large number of patients report pain.
Thus, the use of intracanal medication, especially dexamethasone, plays a fundamental role in endodontic therapy, whose purpose is to inhibit inflammatory responses.
Thus, BASSON et al.,2 comment that special attention should be given during procedures, particularly to intracanal medication on the surface of tubes, which can be contaminated by microorganisms and carried to the surgical field and root canal.
Previously, Silva Júnior et al.1 found the presence of gram-negative bacilli, gram-positive staphylococci, and fungi in 25 of the 38 samples examined, but only in unused anesthetic tubes. This contamination originated from the rubber and metal caps of the tubes that were improperly stored and inadequately transported. In fact, the aforementioned authors confirm that piercing the cap with the needle transfers microorganisms to the contents of the tube and subsequently causes infections when applied to the patient.
Therefore, it is the professional's responsibility to ensure that solutions containing medications do not interfere as agents that cause contamination during endodontic procedures. Care must be taken to ensure that patients are treated with care so that infection does not occur during intra-canal medication application procedures.
That said, Pauletti et al.,11 analyzing the effectiveness of disinfecting 31 anesthetic tubes, used 70% alcohol (A), iodine compound (I), 0.12% aqueous chlorhexidine digluconate solution (CA 0.12%), 2% aqueous chlorhexidine digluconate solution (CA 2%), 0.12% chlorhexidine digluconate alcoholic solution (CAL 0.12%), and 2% chlorhexidine digluconate alcoholic solution (CAL 2%) for exposure times of 5, 10, and 15 minutes to the disinfecting agents. They concluded that the agents tested that demonstrated disinfection efficacy in just 5 minutes, combined with low cost and ease of handling, were: I, CA 2%, CAL 0.12%, CAL 2%, which demonstrates the need for and ease of disinfecting these tubes before use.
In turn, Dutra et al.,12 evaluating the effectiveness of disinfectant solutions for microorganisms in anesthetic tubes, used 70% ethyl alcohol, 7% stabilized chlorine dioxide, and 5.2% benzalkonium chloride with 3.5% polyhexamethylene biguanide. The 70% alcohol and 3.5% polyhexamethylene biguanide proved effective in disinfecting the tubes when applied by rubbing for 10, 20, and 30 seconds, being more efficient than the 7% stabilized chlorine dioxide, which showed microbial growth even with the rubbing methods. As for the immersion method, none of the three disinfectants showed satisfactory results.
It is important to note that after opening the packages, the anesthetic tubes are stored in their own boxes, remaining exposed to the environment, favoring contamination of the external surface and transforming the tubes into potential sources of cross-infection, which supports Oliveira20 in confirming that such decontamination of materials used in dentistry is essential to ensure the safety of both service users and health professionals.
Cross-infection, also known as cross-contamination, refers to the spread of pathogens such as bacteria, viruses, and parasites from one source to another, either through direct contact between individuals, contaminated areas, equipment, or through the air. This transmission can occur in various environments, including hospitals, dental offices, kitchens, and other places where there is a risk of contamination. Cross-infection in dental offices can occur between patients and healthcare professionals, especially through contaminated devices and surfaces. It is essential to strictly adopt hygiene and disinfection protocols to prevent transmission. Cross-infection prevention involves measures such as hand hygiene, such as frequent hand washing, proper cleaning and disinfection of surfaces, equipment, and materials, which reduces the risk of contamination, and use of personal protective equipment (PPE) such as gloves and masks to protect both the professional and the patient. proper disposal of infectious waste in appropriate locations to prevent the spread of pathogens, isolation of patients with contagious infections to prevent spread to others, and education and awareness so that healthcare professionals and the general population are aware of the risks of cross-infection and preventive measures. By adopting these measures, it is possible to significantly reduce the risk of cross-infection and protect public health.
It is therefore the sole responsibility of the endodontist to ensure that solutions containing medications do not interfere as agents that produce contamination during endodontic interventions.
Pimentel et al.,7 Dutra et al.,12 Santos and Salles,19 and Oliveira20 explain that cleaning and disinfecting dental instruments aims to eradicate pathogenic bacteria and prevent infections. Evidently, due to the contact with saliva and blood during dental procedures, there is a high risk of disease transmission, which makes sanitization essential in combating cross-infection. The occurrence of cross-contamination in a dental office environment, that is, when microorganisms are transferred from a contaminated environment to another, either through direct or indirect contact, can lead to infections that can occur in various ways, such as contaminated hands of healthcare professionals, poorly sanitized surfaces, shared medical equipment, and even through the air. Although microorganisms can remain in places for long periods of time even outside their fluids, it can be said that if prevention standards are not adopted, the transmission of pathogens between patients, dentists, auxiliary staff, and dental technicians can occur frequently.
Knowing that, in clinical practice, the medication tube is designed for multiple uses, it should be filled with a smaller amount of medication sufficient for use in the same patient, followed by immediate disposal. In addition, improper storage in drawers and, as pointed out by Haddad et al.,8 in cases without prior disinfection, considering the handling, will enable cross-contamination and, with this in mind, it is necessary to question whether the biosafety of this procedure is being preserved.
Dutra et al.,12 pointed out that sterilization is defined as the process of completely eliminating all microorganisms present in a material. This term is absolute, meaning that an object or substance is either sterilized or not; there are no intermediate levels of sterilization. On the other hand, disinfection is the procedure that aims to eliminate only pathogenic microorganisms, without necessarily removing all microorganisms present. Disinfection is applied to inanimate objects, such as surfaces, instruments, and some materials used in procedures, such as anesthetic tubes, which cannot be sterilized. In practice, the goal of disinfection is to reduce the number of microorganisms to an amount considered safe. Disinfectants are classified according to their effectiveness into three categories: high level, intermediate level, and low level.
Based on the risk of infection transmission associated with the use of items in healthcare procedures, there is a classification in Brazil, which has been incorporated by the Brazilian Health Regulatory Agency (ANVISA)4 into its regulations, establishing guidelines for the reprocessing of medical products.
This investigation shows that cross-contamination occurs very easily, including on surfaces. However, it seems that adequate conduct and exposure to the risk that may occur for many health professionals and academics has not been sufficient.
Given the above, even more alarming than the compromise of endodontic treatment is the danger of cross-transmission of pathogens. Thus, the research by Pimentel et al.7 collected data on the control of cross-infection in the country and demonstrated that dental students and professionals do not correctly apply biosafety measures in their clinical routine, in addition to sterilization procedures that have proven to be flawed and lacking standards among dentists.
According to Jesus and Câmara,15 introducing concepts and values related to biosafety during academic training is more effective than trying to modify them after professionals enter the job market. This refers to the construction of a culture of responsibility, since behaviors and virtues practiced during undergraduate studies are incorporated and maintained throughout professional careers.
Thus, the authors endorse that the inclusion of a biosafety course in the undergraduate curriculum would have a positive impact on the development of safe behaviors from the beginning of the professional career.
The disinfection of surfaces such as countertops, peripherals, equipment, drawers, storage and transport cases for products, among others, should be the first protocol to be considered. In fact, Haddad Filho,8 when evaluating cases carried by students to store their dental materials, concluded that such packaging needs to be properly disinfected, especially their internal surfaces as well as the materials contained therein, in order to prevent the spread of microorganisms, including those considered moderate to high risk pathogens. As a practical and efficient disinfection measure, the study analyzed the use of silver nanoparticles as a resource before placing the materials on the clinical table.
During a clinical internship day for University students, to complement the study, an NDP® tube was selected for analysis of its external surface. The tube, which would be used in the treatments during that period, had its external surface rolled over the culture medium before and after handling. In this study, we observed that the NDP® tube under evaluation had a contaminated external surface, which became more severe after use with microorganisms from the environment and oral environment. This contamination was most likely due to contact with the surfaces, although it did not come into contact with the patient's mucosa due to the strict isolation.
It is very likely that this contamination was not amplified from the patient's oral environment, considering the use of strict isolation, but from the operator's external handling, demonstrating deficiencies in aseptic practices and material handling. This finding highlights the importance of adopting biosafety protocols, including proper hand hygiene, correct glove use, and careful handling of supplies, even when the surgical field is strictly isolated. Such measures are essential to prevent the introduction of microorganisms during clinical procedures and to ensure the safety of both the patient and the dental team.
Furthermore, Ranjbari et al.,9 confirmed that infection control is an important aspect in dentistry, especially in oral and maxillofacial surgery, where infection control is crucial, making a sterile surgical set essential.
Manufacturers only ensure the sterility of the anesthetic, but not the sterility of the external surface of the cartridge. Therefore, they recommend alcohol and other disinfectants such as aqueous chlorhexidine and alcoholic chlorhexidine11,12,18 to sterilize the external surface, especially the cartridge diaphragm. Of course, research has shown contamination of the external surfaces of intra-canal medication cartridges in various quantities by different types of microorganisms, and it should not be ignored that direct inclusion in the set of materials to be used during endodontic procedures is not included, especially the reuse of tubes without prior sterilization, a fact evidenced by Mondini et al.,18 since infections produced at the site during clinical procedures.
And to think that, if not properly disinfected after the end of the procedure for storage, it can contaminate all other items in the case or dental clinic drawers, compromising the surgical field for other procedures performed by the dentist, not just endodontic treatment. In turn, Silva Júnior et al.,1 and Silva Junior et al.,16 demonstrated that the transport, through needle insertion, of microorganisms from the surface to the interior of virgin dental anesthetic tubes, originating from the tubes' rubber and metal caps, as a result of improper storage and transportation, can cause possible infections. This reinforces the idea that, due to failures in the biosafety chain and breaches of the aseptic barrier, materials can become vectors of infection due to human or environmental errors.
Observing that microorganisms can enter NDP® intracanal medicated tubes after use, considering the needle puncture in the plunger that transports microorganisms from the external surface or supposedly aspirates fluids, raises significant concerns about real-life clinical conditions, which present deficiencies in clinical handling and storage. The tubes that did not show microbial growth after use suggest that the operator handling them is more attentive to biosafety precautions than those that did present contamination. Furthermore, the antimicrobial action of the agent present is not sufficient to completely inactivate such contaminants, although paramonochlorophenol (PMC) has recognized antimicrobial activity.
The persistence of these microorganisms inside the tube, even after contact with the PMC, followed by the alleged reuse of this material on different patients on the same day, may represent a potential risk of cross-contamination, in addition to considering that the tube may have been used in a short interval between appointments. Therefore, according to Haddad Filho et al.,5 several infectious diseases pose significant risks in the dental clinical environment, such as chickenpox, hepatitis B and C, herpes conjunctivitis, herpes simplex virus, shingles, infectious mononucleosis, measles, rubella, mumps, influenza, human papillomavirus (HPV), cytomegalovirus, human immunodeficiency virus (HIV), and other bacterial and fungal infections.
This finding highlights the need to review clinical practices related to the storage, transportation, and reuse of tubes, as well as the importance of adopting strict disinfection protocols for these materials. The threat of spreading infectious agents among patients goes beyond individual responsibility and becomes a collective health problem, requiring training for healthcare professionals to ensure a truly safe clinical environment.
The professional should adopt, at a minimum, a disinfection protocol with solutions that are effective in maximizing the elimination of microorganisms, either by soaking the tube for a sufficient period of time or by rubbing the agent on the outside of the tube with sterile gauze. A study by Porto6 on the effect of silver nanoparticles on pathogens concluded that it is an effective disinfectant and can be an alternative to commonly used disinfectants, due to its strong antimicrobial potential, low cost, and ease of availability.
Considering that the procedures were performed in strict isolation, the most likely hypothesis is that oral microorganisms were introduced into the tubes through contact with contaminated surfaces or improper handling, rather than directly through exposure to the oral environment. This finding reinforces the severity of patients' exposure to the risk of cross-contamination, compromising not only the success of endodontic treatment but also biological safety in the dental environment.
Therefore, to ensure adequate biosafety during the procedure, dentists are advised to adopt an effective disinfection protocol with proven antimicrobial agents, such as silver nanoparticles, either by rubbing with sterile gauze or by immersion for a sufficient period of time. However, in the pursuit of a safer and more easily adhered to protocol in clinical practice, it is concluded that NDP® medication tubes should not be reused and should be discarded after their first and only use, like anesthetic tubes. Therefore, manufacturers are advised to develop single-use tubes with a reduced volume of 0.3 to 0.5 mL, sufficient for a single application and immediate disposal, to avoid waste and ensure the microbiological safety of the procedure.
Based on the results obtained, it is concluded that the reuse of tubes poses a significant biological risk and that strict disinfection protocols must be adopted. Single-use NDP® medication tubes are recommended, along with the development of reduced-volume packaging and immediate disposal, as a preventive measure to ensure biosafety in dental care. Of the total number of NDP® Intracanal Medication tubes evaluated, 57.14% were contaminated by bacteria and fungi from the environment and 42.86% were contaminated by microorganisms likely originating from the oral microbiota, highlighting flaws in handling and storage during clinical care
Nothing.
All data analyzed during this investigation are available from the corresponding author upon reasonable request.
All data analyzed during this investigation are available from the corresponding author upon reasonable request. The authors report no conflicts of interest regarding any of the products or companies discussed in this article.
None.
The authors declare that there are no conflicts of interest.

©2025 Filho, et al. This is an open access article distributed under the terms of the, which permits unrestricted use, distribution, and build upon your work non-commercially.